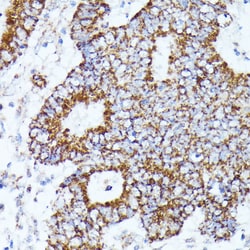
Invitrogen AKR1C2 Polyclonal Antibody 100 &mu;L; Unconjugated:Antibodies,
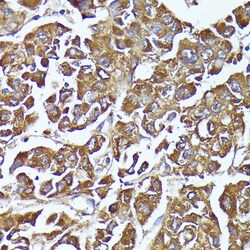
Invitrogen AKR1C2 Polyclonal Antibody 100 &mu;L; Unconjugated:Antibodies,
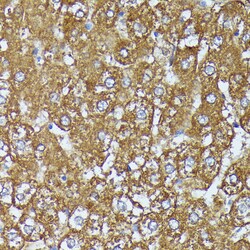
Invitrogen AKR1C2 Polyclonal Antibody 100 &mu;L; Unconjugated:Antibodies,

Learn More
Invitrogen™ AKR1C2 Polyclonal Antibody


Rabbit Polyclonal Antibody
Brand: Invitrogen™ PA587930
Description
Immunogen sequence: MDSKYQCVKL NDGHFMPVLG FGTYAPAEVP KSKALEAVKL AIEAGFHHID SAHVYNNEEQ VGLAIRSKIA DGSVKREDIF YTSKLWSNSH RPELVRPALE RSLKNLQLDY VDLYLIHFPV SVKPGEEVIP KDENGKILFD TVDLCATWEA MEKCKDAGLA KSIGVSNFNH RLLEMILNKP GLKYKPVCNQ VECHPYFNQR KLLDFCKSKD IVLVAYSALG SHREEPWVDP NSPVLLEDPV LCALAKKHKR TPALIALRYQ LQRGVVVLAK SYNEQRIRQN VQVFEFQLTS EEMKAIDGLN RNVRYLTLDI FAGPPNYPFS DEY; Positive Samples: HT-29, A549, Mouse liver; Cellular Location: Cytoplasm.
DD1 is also designated AKR1C1, DDH or DDH1, while DD2 also can be designated AKR1C2, dDD, BABP or DDH2. AKR1C3 and 3 alpha-HSD are alternate designations for human DD3 (which is referred to as AKR1C18 in rodents), while DD4 also can be called AKR1C4, CD, CHDR or AKR1C6 (in rodents). DD1 and DD2 are 20 alpha-HSDs, whereas DD3 and DD4 are the 3 alpha- HSDs. The multiple human cytosolic dihydrodiol dehydrogenases are involved in the metabolism of xenobiotics, such as polycyclic aromatic hydrocarbons, pesticides and steroid hormones, and are responsible for the reduction of ketone-containing drugs by using NADH or NADPH as a cofactor. The 20 alpha- HSD catalyzes the reaction of Progesterone to the inactive form 20 alpha-hydroxyprogesterone.
Specifications
| AKR1C2 | |
| Polyclonal | |
| Unconjugated | |
| AKR1C2 | |
| 17-alpha-HSD; 17-alpha-hydroxysteroid dehydrogenase; 3 alpha-HSD3; 3(17)alpha-hydroxysteroid dehydrogenase; 3(or 17)-alpha-hydroxysteroid dehydrogenase; 3-alpha-HSD3; 3-alpha-hydroxysteroid dehydrogenase; 9430025F20Rik; AI315367; AKR1C2; Akr1c21; AKR1C-pseudo; Aldo-keto reductase family 1 member C2; aldo-keto reductase family 1 member C21; aldo-keto reductase family 1, member C2; aldo-keto reductase family 1, member C21; BABP; Chlordecone reductase homolog HAKRD; DD; DD/BABP; DD1; DD2; DD-2; DD3; DDH2; Dihydrodiol dehydrogenase 2; dihydrodiol dehydrogenase 2; bile acid binding protein; 3-alpha hydroxysteroid dehydrogenase, type III; dihydrodiol dehydrogenase type 1; Dihydrodiol dehydrogenase type 3; Dihydrodiol dehydrogenase/bile acid-binding protein; HAKRD; HBAB; HSD3-3 alpha; HSD3-alpha3; MCDR2; pseudo-chlordecone reductase; SRXY8; TDD; testicular 17,20-desmolase deficiency; trans-1,2-dihydrobenzene-1,2-diol dehydrogenase; type II dihydrodiol dehydrogenase; Type III 3-alpha-hydroxysteroid dehydrogenase | |
| Rabbit | |
| Affinity Chromatography | |
| RUO | |
| 1646, 291283, 77337 | |
| -20°C, Avoid Freeze/Thaw Cycles | |
| Liquid |
| ELISA, Immunohistochemistry (Paraffin), Western Blot, Immunocytochemistry | |
| 2.92 mg/mL | |
| PBS with 50% glycerol and 0.05% ProClin 300; pH 7.3 | |
| P52895, Q6AYQ2, Q91WR5 | |
| AKR1C2, Akr1c21 | |
| Recombinant fusion protein containing a sequence corresponding to amino acids 1-323 of human AKR1C2 (NP_9953171). | |
| 100 μL | |
| Primary | |
| Human, Mouse, Rat | |
| Antibody | |
| IgG |
Your input is important to us. Please complete this form to provide feedback related to the content on this product.